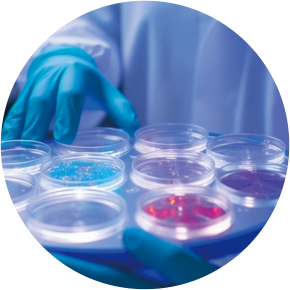

公司业务范围覆盖了从智慧实验室规范建设、信息处理到生物样本交接、前处理(预处理)、培养、质控、贮存,以及基于物联网及云数据的智慧实验室管理系统、实验室后评估等智慧实验室全生命周期流程。
-
行业前沿
寻找成长性和市场空间打开的投资机会
2023年2月,中共中央办公厅、国务院办公厅印发《关于进一步深化改革促进乡村医疗卫生体系健康发展的意见》指出,以基层为重点,以体制机制改革为驱动,加快县域优质医疗卫生资源扩容和均衡布局,推动重心下移、资源下沉。在2023年政府工作报告中也提出“推动优质医疗资源扩容下沉和区域均衡布局。”
-
国内创新药市场蓬勃发展持续性创新动能增强
中国创新药市场发展如何?其实从全球范围来看,创新药的需求是很大的。然而中国大部分企业都在初创期,即便有了优秀的产品,但要同时应对高额研发投入和国际化推广是非常困难的。如果有更好的生长土壤,让种子企业积攒足够的力量去参与竞争,中国药企的竞争力就会增强。
-
以创新驱动助力医疗器械产业“加速跑”
风起潮涌好扬帆。经开区正抢抓新的发展机遇,围绕重点领域集中发力,向着全力构建医疗器械特色产业集群的宏伟蓝图阔步向前,力争到“十四五”末期,将示范园打造成为行业领先、国内一流、国际知名的医疗器械产业发展引领示范区。